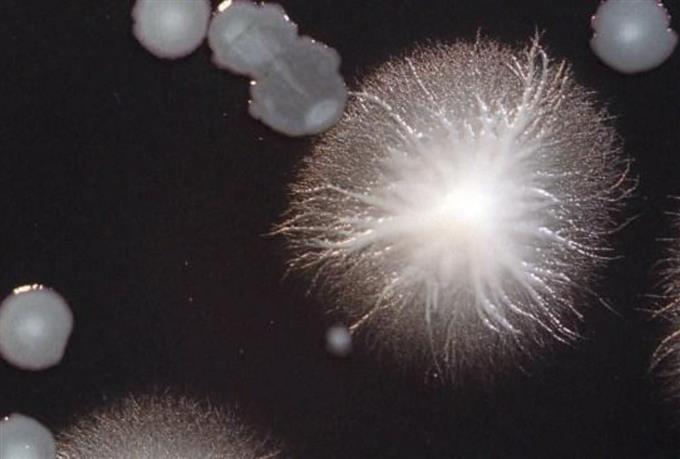

Καθηγητής ΑΠΘ για πανώλη: Τεράστιος ο κίνδυνος για ισχυρό πλήγμα στην οικονομία - Οι τρόποι μετάδοσης
Κατά τον καθηγητή Μικροβιολογίας και Λοιμωδών Νοσημάτων των Ζώων της Κτηνιατρικής Σχολής του ΑΠΘ, Σπύρο Κρήτα, η πανώλη μπορεί να μεταδοθεί με διάφορους τρόπους στα ζώα, ακόμα και με την ακούσια «μεσολάβηση» ανθρώπων
Loading...